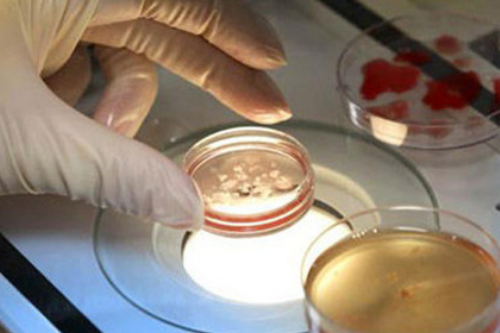
代妈市生育保险定点医疗机构名单,(榜单)代妈做试管成功率高的医院

在香港圣保禄医院验血不会不准,很多黑中介会以香港验血能查男女为噱头吸引孕妇,收取费用后会通过某种手段取得一个假的检查单,然后再它交给孕妇,甚至也有的中介并不会按照要求将母体血液邮寄到香港,而是将血液扔掉,然后直接人间蒸发,虽然香港验血查男女合法,但还是建议孕妇最好亲自前往香港。但是我们的国家是一个国家,两种制度。虽然在内地无法检测婴儿性别,但在香港是合法的。很多内地夫妇都想提前知道胎儿的性别,可以去香港验血检查宝宝的性别。但是在网上搜了一下,很多香港验血不准确的头条文章,如果不点开仔细看看的朋友,会误解香港验血的准确性。比如香港验血有y却生了女儿,但深究的话,这些出现失误的检查肯定是因为隐藏了什么所以才不准!代妈市生育保险定点医疗机构名单,(榜单)代妈做试管成功率高的医院
代妈生育保险实行定点医疗制度,也就是说在确定怀孕后,应事先在代妈市范围内生育险定点医疗机构内选定产检的医疗机构,并办理就医确认手续。否则就医确认前的产前检查费不报销。整理代妈市生育保险定点医疗机构名单如下:
客观因素:生活环境突变导致长期精神紧张;高空、高温、超强度作业和从事放射工作的精神和环境因素。严重营养不良如维生素A、E缺乏,微量元素如锌、锰缺乏,钙磷代谢紊乱等营养因素。酒精、棉籽油中的汞、砷、铅、尼古丁等有毒物质的慢性中毒,化疗和药物治疗等。,可能是男性不育的原因。
此外,内分泌疾病也是男性不育的原因,如垂体性侏儒症、肥胖不育综合征、垂体功能减退、先天性性腺发育不良、先天性无精子综合征、高泌乳素血症、垂体瘤或颅内感染等因素也存在。
我相信,不管是什么样的疾病,只要能及早治疗,就能有效控制病情的发展。那么我们就能更好地理解。以上是对男性不育症状的介绍。现在你应该有所了解了。男性不育的出现,不仅影响男性健康,还会让很多家庭陷入不育的危害中。所以要对不孕不育有正确的认识,积极治疗。今天的治疗试管婴儿医院就是以上。希望对大家有帮助。
在国内单身女性是不能做试管婴儿的!首先,做试管婴儿需要满足的三个条件:结婚证、准生证、身份证单身女性想要做试管婴儿只有去国外,例如美国、泰国、俄罗斯等国际,或者是在国内找一些中介来操作试管婴儿!
我可以帮你
自1978年世界上首例试管婴儿诞生以来,试管婴儿技术不断创新,经历了一代、二代、三代的迭代发展。
一代试管婴儿,即体外受精-胚胎移植(IVF)技术,利用精子和卵子在培养基中自然结合的方法解决了女性不孕的问题;
二代试管婴儿,即卵胞浆内单精子显微注射(ICSI)技术,借助显微操作系统将筛选出的单个优质精子注入卵子内使其受精,解决了男性不育的问题;
三代试管婴儿,即胚胎植入前遗传学检测(PGT),在ICSI的基础上通过基因筛选的方式挑选正常的胚胎植入母体。
与前两代产品相比,三代试管婴儿PGT技术能够帮助生育困难的夫妻(女方高龄、不明原因反复自然流产3次及以上、3次及以上试管婴儿植入失败、严重畸精子症、携带单基因遗传病、染色体结构异常等适应症)进行胚胎筛选,提高试管婴儿技术的助孕成功率,降低流产率。
三代试管技术的新名字,PGS/PGD到PGT:“PGD”中的“D”代表“诊断”,用临床术语“诊断”来描述胚胎检测,太过绝对而显的不太合适,而且不能区分检测的具体内容和不同的适应证。“S”代表“筛查”,命名太笼统,没有确切含义。
为了更好的国际交流和学术研讨,2026年美国生殖医学学会(ASRM)、欧洲人类生殖和胚胎学会(ESHRE)等国际学术组织共同发出倡议,建议采用新的术语来描述“第三代试管婴儿”,即“Preimplantation Genetic Testing”,简称“PGT”。
“PGT”中的“T”代表“检测”,相对于“D(诊断)”或者“S(筛查)”更加严谨和准确。但是,单纯用“T”同样不能区分“第三代试管婴儿”的不同适应证。
“PGT”新命名(新的命名更加清晰明了,且更加严谨科学。)
PGT-A,全称Preimplantation Genetic Testing for Aneuploidies,其目的是为了提高临床IVF的成功率,进行胚胎染色体非整倍体筛查,相当于旧名称中的“PGS”;(提高活产率、降低不良妊娠率、预防染色体综合征)
PGT-M,全称Preimplantation Genetic Testing for Monogenic/Single Gene Defects,是指针单基因疾病生育风险者,比如说孟德尔遗传病、HLA配型选择、肿瘤易感基因剔除等,其目的是用于靶向地检测胚胎是否携带某些可导致单基因病的突变基因。相当于PGD中检测单基因病的一部分;(靶向阻断单基因遗传病)
PGT-SR,全称Preimplantation Genetic Testing for Chromosomal Structural Rearrangements,是指夫妻双方或之一存在染色体结构重组者,其目的是用于靶向地检测胚胎染色体是否存在结构异常,比如倒位、平衡易位和罗氏易位。相当于PGD中检测胚胎染色体结构异常的部分。(阻断染色体结构异常的遗传)
总而言之,“PGD”和“PGS”是以往的概念,慢慢会被弃用,取而代之的是 “PGT-SR”、“PGT-M”、“PGT-A”。随着NGS技术在临床的广泛应用,目前针对染色体异常或者单基因缺陷生育风险夫妇进行的PGT-SR或者PGT-M,常常会默认同时行PGT-A,以期提高胚胎的种植率和持续妊娠率。
全国具备三代试管资质的医院
截止2026年12月31日,我国已有80家医疗机构具有提供PGT服务的资质。
从分布地区来看,PGT医疗机构主要分布在各省市的顶级医院;
从数量上来看,广东省PGT医疗机构最多,数量达10家,随后是江苏省、代妈市、湖北省,分别有7家、7家以及5家。
| PGT资质医院列表 | ||
| 区域 | 医院 | 周期数(个) |
| 代妈市 | 代妈大学第三医院 | 20000 |
| 解放军总医院第一医学中心(原301医院) | 2000 | |
| 解放军总医院第六医学中心(原海军总院) | 2000 | |
| 代妈市 | 代妈交通大学医学院附属仁济医院 | 7000 |
| 代妈集爱遗传与不育诊疗中心 | 7000 | |
| 代妈市第一妇婴保健院 | 5000 | |
| 中国福利会国际和平妇幼保健院 | 4500 | |
| 海军军医大学附属长海医院 | 3000 | |
| 代妈长征医院 | 2000 | |
| 代妈交通大学医学院附属瑞金医院 | 2000 | |
| 广东省 | 中山大学附属第一医院 | 4500 |
| 中山大学附属第六医院 | 5000 | |
| 代妈医科大学附属第三医院 | 8000 | |
| 广东省妇幼保健院 | 3000 | |
| 中山大学孙逸仙纪念医院 | 3000 | |
| 代妈市妇幼保健院 | 2000 | |
| 代妈市妇女儿童医疗中心 | 2000 | |
| 中山市博爱医院 | 2000 | |
| 代妈大学代妈医院 | 2000 | |
| 珠海市妇幼保健院 | 2500 | |
| 重庆市 | 重庆市妇幼保健院 | 6000 |
| 第三军医大学附属西南医院 | 2000 | |
| 江苏省 | 江苏省人民医院(江苏省妇幼保健院) | 6000 |
| 南京鼓楼医院 | 6000 | |
| 南京市妇幼保健院 | 4000 | |
| 徐州市妇幼保健院 | 1500 | |
| 苏州市立医院 | 2000 | |
| 苏州大学附属第一医院 | 1000 | |
| 南京军区总医院 | 1000 | |
| 山东省 | 山东大学附属生殖医院 | 15000 |
| 济宁医学院附属医院 | 1500 | |
| 浙江省 | 浙江大学医学院附属妇产科医院 | 8000 |
| 浙江大学附属邵逸夫医院 | 5000 | |
| 河南省 | 代妈大学第一附属医院 | 8000 |
| 河南省人民医院 | 6000 | |
| 代妈大学第三附属医院 | 5500 | |
| 四川省 | 四川大学华西第二医院 | 6000 |
| 四川省妇幼保健院 | 3000 | |
| 成都市妇女儿童中心医院 | 1500 | |
| 福建省 | 福建省妇幼保健院 | 3000 |
| 联勤保障部队第900医院 | 3000 | |
| 湖北省 | 华中科技大学同济医学院附属同济医院 | 8000 |
| 华中科技大学同济医学院附属协和医院 | 3500 | |
| 代妈大学人民医院 | 4500 | |
| 湖北省妇幼保健院 | 3500 | |
| 十堰市人民医院 | 2500 | |
| 湖南省 | 中信湘雅生殖与遗传专科医院 | 49000 |
| 中南大学湘雅医院 | 4000 | |
| 湘潭市中心医院 | 3500 | |
| 安徽省 | 安徽医科大学第一附属医院 | 6000 |
| 中科大一附院 | 4000 | |
| 解放军第901医院 | 2000 | |
| 河北省 | 河北医科大学第二医院 | 5500 |
| 石家庄市妇产医院(石家庄市第四医院) | 1800 | |
| 陕西省 | 第四军医大学附属唐都医院 | 6000 |
| 西北妇女儿童医院(陕西省妇幼保健院) | 10000 | |
| 江西省 | 江西省妇幼保健院 | 6800 |
| 赣州市妇幼保健院 | 1000 | |
| 辽宁省 | 中国医科大学附属盛京医院 | 5000 |
| 北部战区总医院和平院区(原沈阳军区第202医院) | 3000 | |
| 沈阳市妇婴医院 | 3000 | |
| 云南省 | 云南省第一人民医院 | 7500 |
| 广西省 | 中国人民解放军联勤保障部队第九二四医院(原181医院) | 5000 |
| 柳州市妇幼保健院 | 5000 | |
| 广西壮族自治区妇幼保健院 | 3000 | |
| 贵州省 | 贵阳市妇幼保健院 | 3500 |
| 贵州医科大学附属医院 | 3000 | |
| 山西省 | 山西省妇幼保健院 | 4000 |
| 内蒙古自治区 | 内蒙古医科大学附属医院 | 2000 |
| 赤峰市妇产医院 | 1500 | |
| 天津市 | 天津市中心妇产科医院 | 3000 |
| 新疆省 | 新疆佳音医院 | 3500 |
| 新疆医科大学第一附属医院 | 2800 | |
| 吉林省 | 吉林大学第一医院 | 2500 |
| 甘肃省 | 兰州大学第一医院 | 4000 |
| 甘肃省妇幼保健院 | 3000 | |
| 海南省 | 海南医学院第一附属医院 | 2000 |
| 慈铭博鳌国际医院 | 500 | |
| 宁夏回族自治区 | 宁夏医科大学总医院 | 1600 |
| 香港特别行政区 | 香港中文大学威尔士亲王医院 | 2000 |
(数据
2.不明原因反复自然流产:反复自然流产2次及以上。
3.不明原因反复种植失败:移植3次及以上或移植高评分卵裂期胚胎数4-6个或高评分囊胚数3个及以上均失败。
4.严重畸精症。
5.染色体异常。夫妇任一方或双方通过检测发现携带染色体数目异常,或者结构异常。
6.单基因遗传病。具有生育常染色体显性遗传、常染色体隐性遗传、X连锁显性/隐性遗传、Y连锁遗传等遗传子代高风险的夫妇,且家族中的致病基因突变诊断明确或致病基因连锁标记明确。
7.具有遗传易感性的严重疾病。夫妇任一方或双方携带有严重疾病的遗传易感基因的致病突变,如遗传性乳腺癌的BRCA1基因、BRCA2基因致病突变。
8.人类白细胞抗原配型。曾生育过需要进行骨髓移植治疗的严重血液系统疾病患儿的夫妇,可以通过“第三代试管婴儿”技术,选择生育一个和先前患儿HLA配型相同的同胞,通过从新生儿脐带血中采集造血干细胞进行移植,救治患病同胞。
哪里可以做第三代试管婴儿?爱美女性朋友要想用西红柿瘦身的话,建议在饭前食用,它里面含有的食物纤维不易被人们所吸收,在减少高热量食物吃进去的同时,西红柿还可以阻止身体吸收过多的脂肪。减肥贵在坚持,不要指望一朝一夕就能减下来,要坚持食用才能有成效。标签: